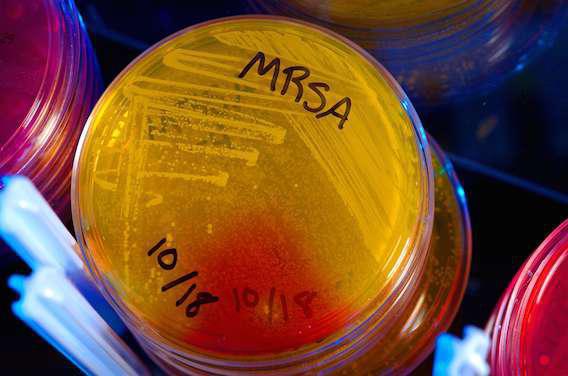

Des rotations d’antibiotiques, c’est la solution qu’on trouvé des chercheurs américains pour lutter contre la résistance des super-bactéries. En utilisant un cycle particulier, les médecins seraient même capables de leur redonner un état antérieur à la résistance. Leurs résultats sont détaillés dans PLOS One. En plus d’offrir l’opportunité de prévenir la formation d’un biofilm, ils démontrent que les antibiotiques, utilisés de manière rationnelle, restent un traitement d’avenir.
Voilà plusieurs années que le fléau de l’antibio-résistance inquiète les experts du monde entier. Il faut dire que la menace est de taille : les « super-bactéries » font régulièrement parler d’elles en causant des épidémies majeures, notamment aux Etats-Unis. L’Organisation Mondiale de la Santé (OMS) a même brandi la menace d’une « ère post-antibiotique. » Mais rien n’y fait : l’Homme consomme toujours trop d’antibiotiques. En Europe, la France est même championne, avec 719 tonnes vendues en 2012.
15 classes d’antibiotiques impliquées
La résistance aux antibiotiques est un phénomène naturel, rappellent les auteurs de cette étude, mais qui atteint une ampleur inégalée. Réduire le recours aux médicaments ne suffit pas. Les experts s’acharnent maintenant à comprendre quand la résistance se forme, comment la prévenir… voire l’inverser. « Puisque l’antibio-résistance est inévitable, nous devons accepter cela et développer des méthodes qui en limitent les conséquences, écrivent les auteurs. Une des approches raisonnables consiste à utiliser les antibiotiques en rotation. »
Après avoir créé une bactérie en laboratoire, les chercheurs ont testé différentes rotations avec 15 classes. L’objectif : trouver la méthode qui, en plus de prévenir le développement d’une résistance, permet d’inverser le phénomène en ramenant les bactéries à leur état d’origine. Grâce à une combinaison de modélisations mathématiques, c’est désormais chose faite.
« Il y a toujours de l’espoir »
Le système est plutôt complexe, puisque la rotation implique 6 antibiotiques différents en même temps. Mais l’impact sur la pratique des médecins, lui, est réel. « Les médecins n’adoptent pas d’approche organisée lorsqu’ils utilisent les antibiotiques en rotation, souligne Miriam Barlow, dernier auteur de l’étude. Ils tireraient profit d’un système éprouvé. Notre objectif était de trouver un programme précis, ordonné auquel les médecins peuvent se fier en sachant qu’à la fin, la résistance sera vaincue et que les antibiotiques fonctionneront. »
La durée de chaque rotation, elle, reste à déterminer. Les chercheurs espèrent la définir grâce à des travaux en collaboration avec des praticiens. « Ce travail montre qu’il y a toujours de l’espoir du côté des antibiotiques si nous les utilisons intelligemment », conclut Miriam Barlow. Une affirmation qui s’applique à d’autres formes de résistance aux médicaments.